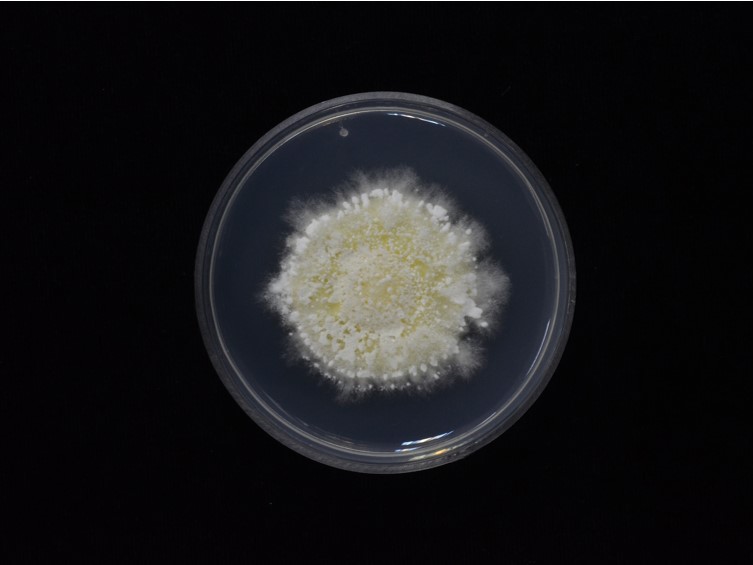

Holotype:
THAILAND, Chanthaburi Province, Khao Soi Dao Wildlife Sanctuary, 1 Jan. 2000, N.L. Hywel-Jones, holotype BBH 13831, ex-type living culture BCC 16585, TBRC 8350.
Habitat:
Leaf litters, buried in the soil.
Host:
Ladybugs, longhorn beetle, earwigs, adult cicada, leafhoppers, stink bug, queen ant, wasps.
Description:
 Stroma arising from the posterior part of Coleoptera larva, cylindrical with rounded apices, yellow when fresh and yellow-orange when dry, 38-50 × 0.8-2.5 mm.
Stroma arising from the posterior part of Coleoptera larva, cylindrical with rounded apices, yellow when fresh and yellow-orange when dry, 38-50 × 0.8-2.5 mm.  Perithecia semi-immersed, ovoid, 420-580 × 150-290 μm.
Perithecia semi-immersed, ovoid, 420-580 × 150-290 μm.  Asci hyaline, cylindrical, capitate, 180-335 × 3-6 μm. Asci-caps hyaline, hemispherical, 2-3 × 3.5-4 μm.
Asci hyaline, cylindrical, capitate, 180-335 × 3-6 μm. Asci-caps hyaline, hemispherical, 2-3 × 3.5-4 μm.  Ascospores hyaline, filiform, multi-septate, 241-320 × 1 μm, breaking into 64 part-spores. Part-spores hyaline, cylindrical with truncated end, 4-23 × 1 μm. Hosts covered with white mycelium, powdery when sporulating.
Ascospores hyaline, filiform, multi-septate, 241-320 × 1 μm, breaking into 64 part-spores. Part-spores hyaline, cylindrical with truncated end, 4-23 × 1 μm. Hosts covered with white mycelium, powdery when sporulating.  Phialides hyaline, solitary, smooth-walled, base ampulliform, mucronate, rostrate, subspherical to lageniform 2-5 × 1.5-4 μm.
Phialides hyaline, solitary, smooth-walled, base ampulliform, mucronate, rostrate, subspherical to lageniform 2-5 × 1.5-4 μm.  Conidia hyaline, smooth-walled, obovoid, ovoid, occasionally globose to subglobose 2.5-6 × 1.5-3 μm.
Conidia hyaline, smooth-walled, obovoid, ovoid, occasionally globose to subglobose 2.5-6 × 1.5-3 μm.
Culture characteristics:
Colony on PDA growth at room temperature attaining a diam of 21−22 mm in 10 d, 30−32 mm in 20 d, surface mycelium dense, convex to the agar surface, floccose, cottony, sporulation starts at 10 d after inoculation, white to green-yellow.
Colony on PDA growth at room temperature attaining a diam of 21−22 mm in 10 d, 30−32 mm in 20 d, surface mycelium dense, convex to the agar surface, floccose, cottony, sporulation starts at 10 d after inoculation, white to green-yellow.
Reference:
Kobmoo N, Arnamnart N, Pootakham W, et al. (2021). The integrative taxonomy of Beauveria asiatica and B. bassiana species complexes with whole-genome sequencing, morphometric and chemical analyses. Persoonia 47: 136–150.
DOI: https://doi.org/10.3767/persoonia.2021.47.04Species |
Strain |
Compound |
Pubchem CID |
Biological activity |
Reference |
|---|
|
Strain |
Bloc | ITS | RPB1 | TEF1 |
|---|---|---|---|---|
| BCC 1442 | MN40521 | MN401640 | MN401566 | MN401468 |
| BCC 1654 | MN401529 | MN401648 | MN401574 | MN401476 |
| BCC 1655 | MN401531 | MN401650 | MN401576 | MN401480 |
| BCC 16585 | MN401522 | MN401641 | MN401567 | MN401469 |
| BCC 1665 | MN401533 | MN401652 | MN401578 | MN401478 |
| BCC 18115 | - | MN401628 | MN401552 | MN401454 |
| BCC 1906 | MN401526 | MN401645 | MN401571 | MN401473 |
| BCC 2044 | MN401532 | MN401651 | MN401577 | MN401479 |
| BCC 2086 | MN401524 | MN401643 | MN401569 | MN401471 |
| BCC 2120 | MN401518 | MN401637 | MN401563 | MN401465 |
| BCC 2676 | MN401516 | MN401635 | MN401561 | MN401463 |
| BCC 31618 | MN401530 | MN401649 | MN401575 | MN401477 |
| BCC 36657 | MN401520 | MN401639 | MN401565 | MN401467 |
| BCC 49762 | MN401523 | MN401642 | MN401568 | MN401470 |
| BCC 56283 | MN401519 | MN401638 | MN401564 | MN401466 |
| BCC 76509 | MN401528 | MN401647 | MN401573 | MN401475 |